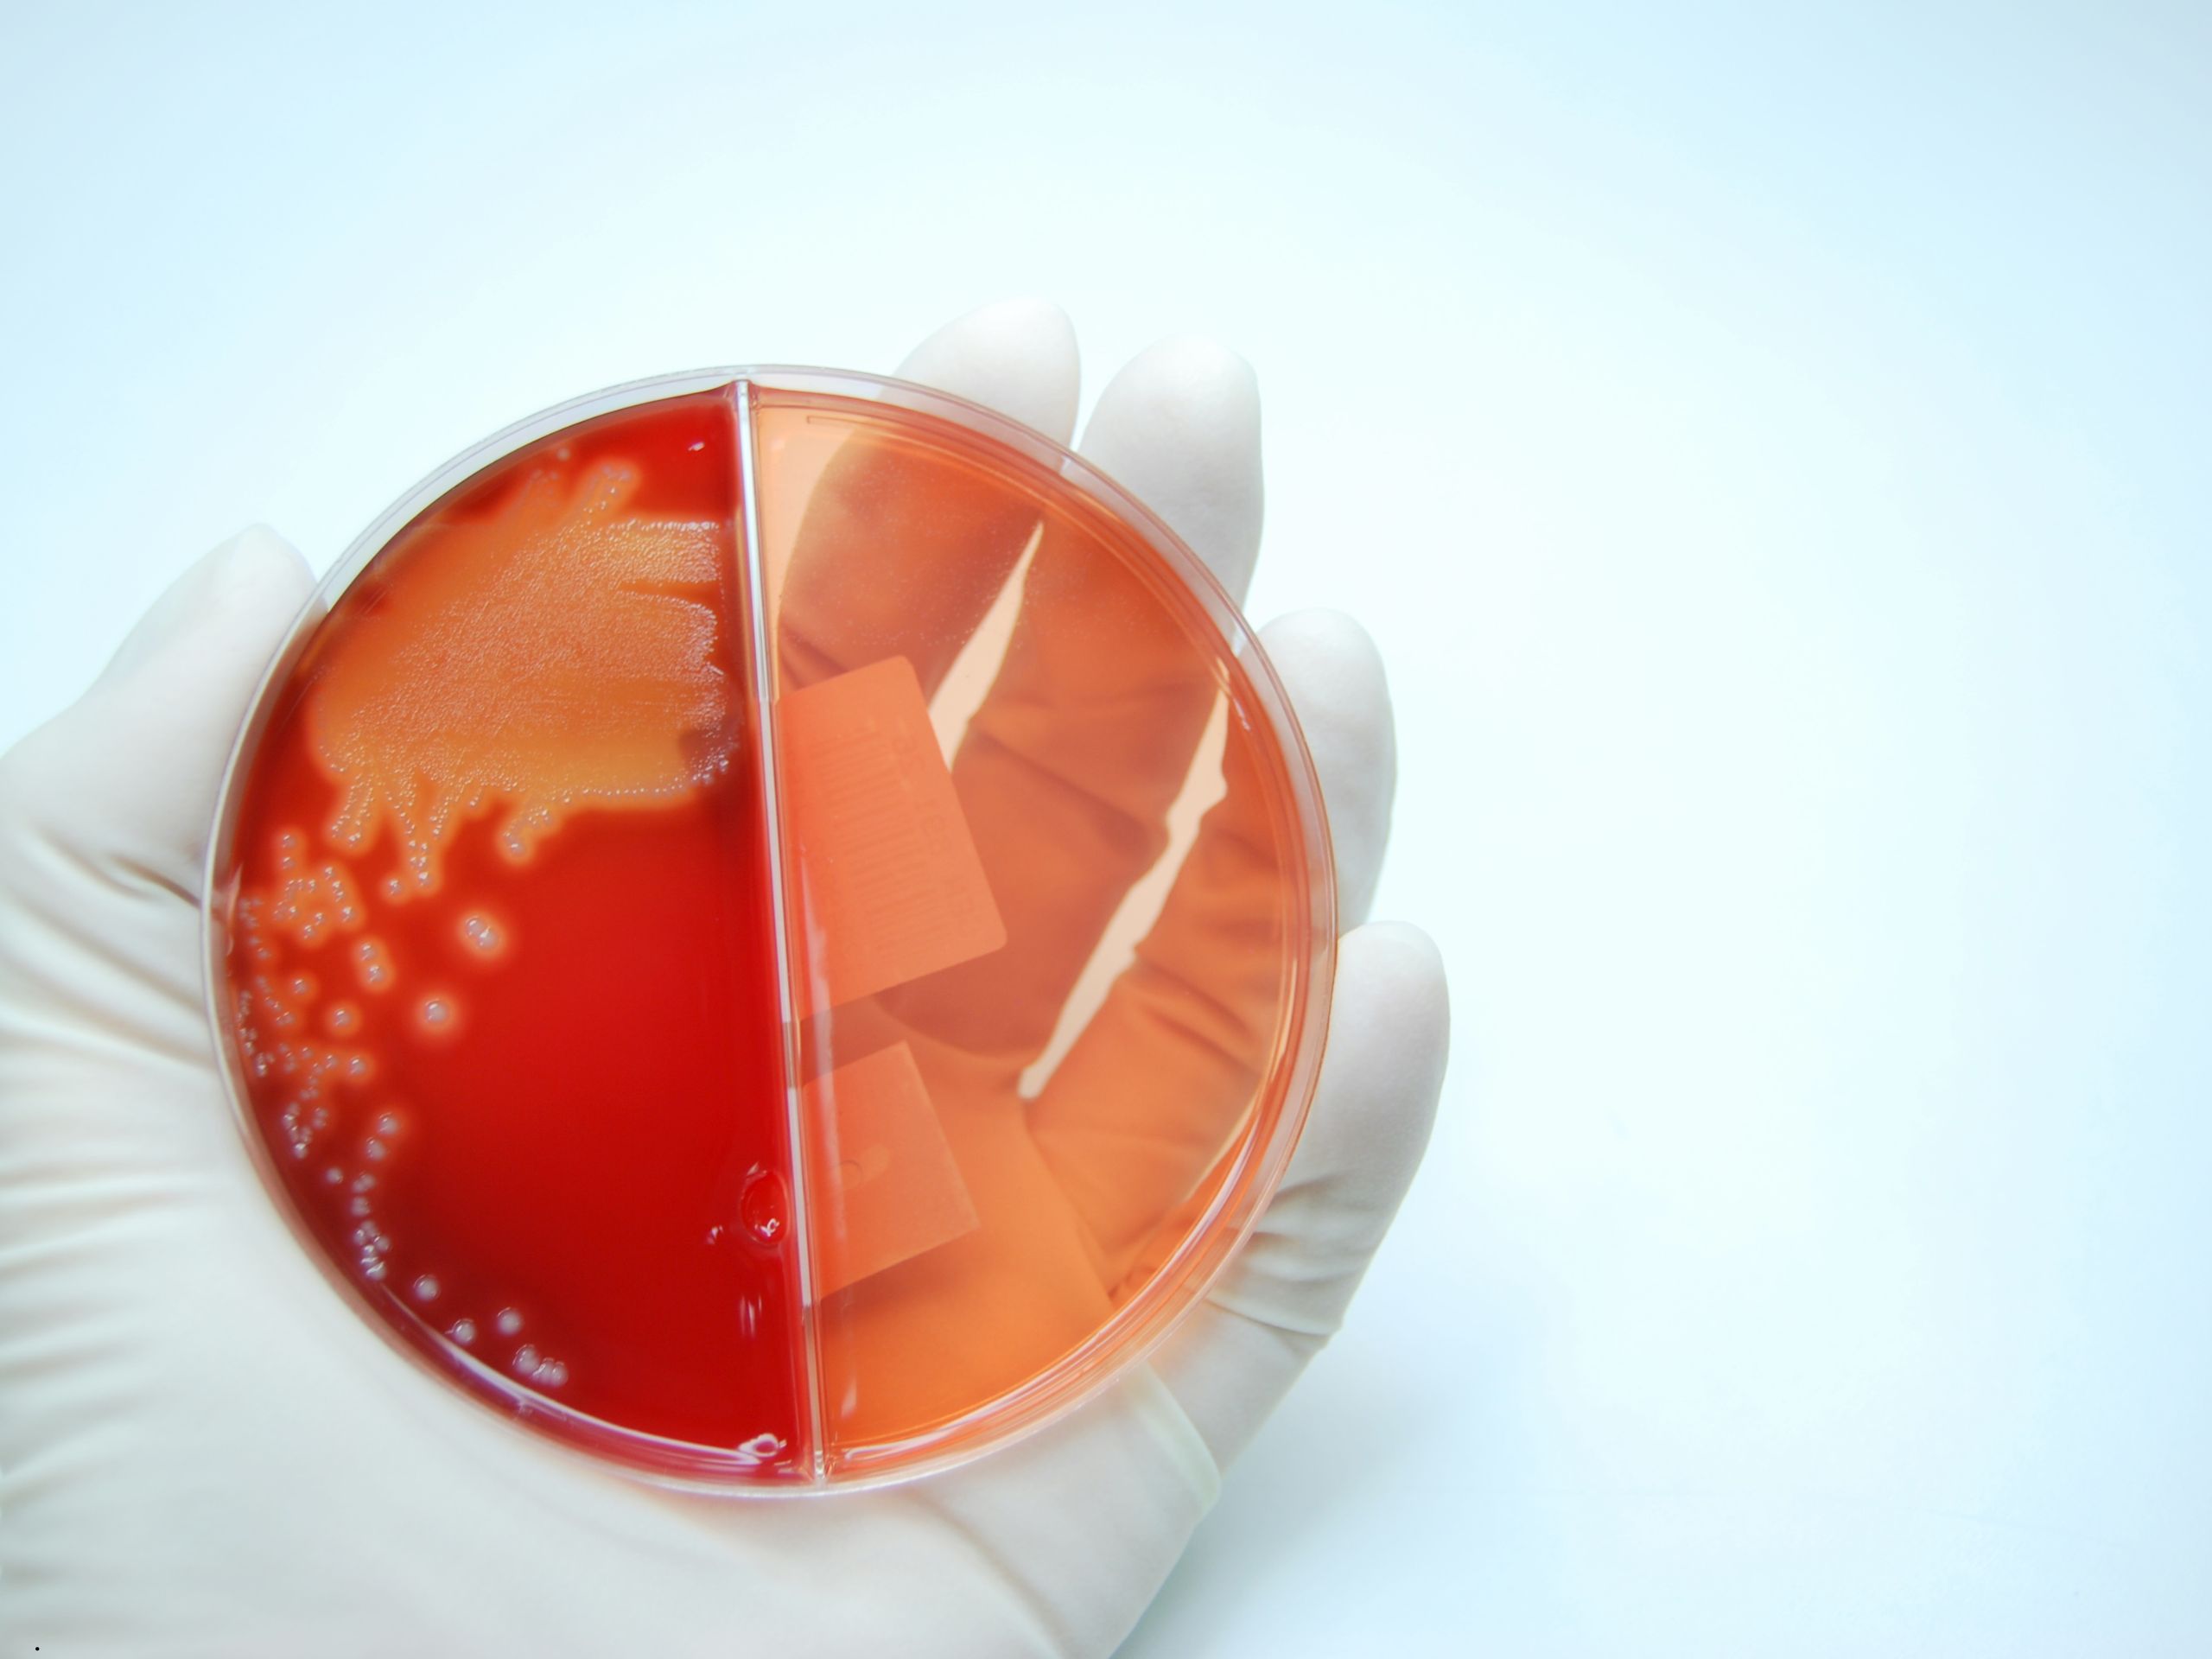

A cultura microbiológica representa ferramenta estratégica fundamental para o controle da mastite bovina
A mastite bovina representa um dos maiores desafios sanitários e econômicos da pecuária leiteira mundial. Esta inflamação da glândula mamária, causada predominantemente por bactérias, compromete a qualidade do leite, reduz a produção e aumenta significativamente os custos operacionais das propriedades.
No Brasil, onde a produção leiteira distribui-se por 98% dos municípios, o controle eficaz da mastite tornou-se requisito fundamental para a sustentabilidade econômica e a competitividade da cadeia produtiva.
Neste contexto, a cultura microbiológica emerge como ferramenta diagnóstica estratégica, permitindo identificar o agente causador da infecção e orientar decisões terapêuticas baseadas em evidências científicas
O que é mastite e por que o diagnóstico microbiológico é fundamental
A mastite bovina é a inflamação do tecido mamário que ocorre quando microrganismos patogênicos penetram na glândula através do canal do teto. Ela se manifesta em duas formas principais: mastite clínica, com sinais visíveis como alterações no leite e inflamação do úbere, e mastite subclínica, sem sintomas aparentes mas detectável através de exames laboratoriais.
A mastite subclínica representa aproximadamente 90% dos casos na propriedade, ocorrendo cerca de 10 casos subclínicos para cada caso clínico identificado. Esta proporção demonstra que a maioria das infecções permanece invisível ao produtor, causando prejuízos silenciosos através da redução da produção de leite, diminuição da qualidade e custos elevados com tratamentos inadequados.
Por que a cultura microbiológica é essencial
Estudos da Universidade Estadual do Norte do Paraná demonstram que mais de 40% dos casos de mastite não necessitam de tratamento com antibióticos. Esta constatação revoluciona a abordagem terapêutica tradicional, na qual o tratamento indiscriminado com antimicrobianos era a prática padrão.
A cultura microbiológica permite identificar precisamente o agente causador da infecção, possibilitando três decisões estratégicas: tratar com antibiótico específico quando necessário, não tratar quando o agente não responde a antimicrobianos ou a infecção pode se resolver espontaneamente, e implementar medidas preventivas direcionadas conforme o perfil microbiológico da propriedade.
Cultura na mastite clínica x subclínica
Mastite clínica
O uso da cultura permite:
- Decidir se o tratamento antibiótico é necessário
- Reduzir o tempo de descarte de leite
- Aumentar a taxa de cura clínica e bacteriológica
- Sistemas de cultura na fazenda têm sido cada vez mais utilizados para essa finalidade.
Mastite subclínica
Nesse caso, a cultura é essencial para:
- Decidir sobre tratamento na lactação ou na secagem
- Identificar animais crônicos
- Definir estratégias de descarte seletivo
- É uma ferramenta-chave para reduzir CCS de forma consistente.
Cultura microbiológica na secagem seletiva
A cultura é um dos pilares da secagem seletiva, prática cada vez mais adotada. Com base nos resultados, é possível:
- Usar antibiótico apenas em vacas infectadas
- Utilizar selante interno em vacas sadias
- Reduzir custos e uso de medicamentos
Além de econômica, essa estratégia melhora os indicadores de qualidade do leite.
Pontos críticos para bons resultados
Para que a cultura microbiológica seja eficiente, alguns cuidados são fundamentais:
- Coleta correta da amostra (assepsia rigorosa)
- Identificação adequada do animal
- Envio rápido ao laboratório ou incubação correta
- Interpretação técnica dos resultados
Sem esses cuidados, o risco de resultados inconclusivos aumenta.
Cultura microbiológica: custo ou investimento?
Embora tenha um custo direto, a cultura microbiológica se paga rapidamente ao:
- Reduzir tratamentos desnecessários
- Diminuir descarte de leite
- Melhorar a CCS do tanque
- Apoiar decisões mais estratégicas
Em sistemas bem geridos, ela deixa de ser um gasto e passa a ser um indicador de eficiência sanitária.
Conclusão
A cultura microbiológica representa ferramenta estratégica fundamental para o controle moderno da mastite bovina. Sua implementação permite transição de abordagem empírica e indiscriminada de tratamentos para gestão baseada em evidências, orientando decisões terapêuticas racionais que beneficiam simultaneamente a saúde animal, a economia da propriedade e a saúde pública.
Em 2026, decisões baseadas em evidências não são mais diferencial — são requisito.
![]()
Deseja receber e ler conteúdos exclusivos como esse em primeira mão?
Participe do nosso grupo de WhatsApp do Esteio Gestão.
Clique aqui e abra a porteira do conhecimento!
Ao clicar no link para ingressar em nosso grupo de WhatsApp, você está concordando em compartilhar seu contato para fins exclusivos de comunicação relacionada ao grupo, conforme autorizado pela Lei Geral de Proteção de Dados (Lei nº 13.709/2018). Seu número será tratado com segurança e privacidade, em total conformidade com a legislação.
Autor:

Eduarda Viana
Zootecnista
Ficou curioso e quer aprender mais sobre pecuária?
Leia mais em: https://esteiogestao.com.br/blog/
Use um sistema que te permite acessar as informações a qualquer momento e em qualquer lugar.
Você é produtor e quer gerenciar o seu negócio de forma prática e rápida? Conheça as nossas soluções agropecuárias em: https://esteiogestao.com.br/produtos-servicos
Nos acompanhe nas redes sociais e fique por dentro de todas as novidades.









